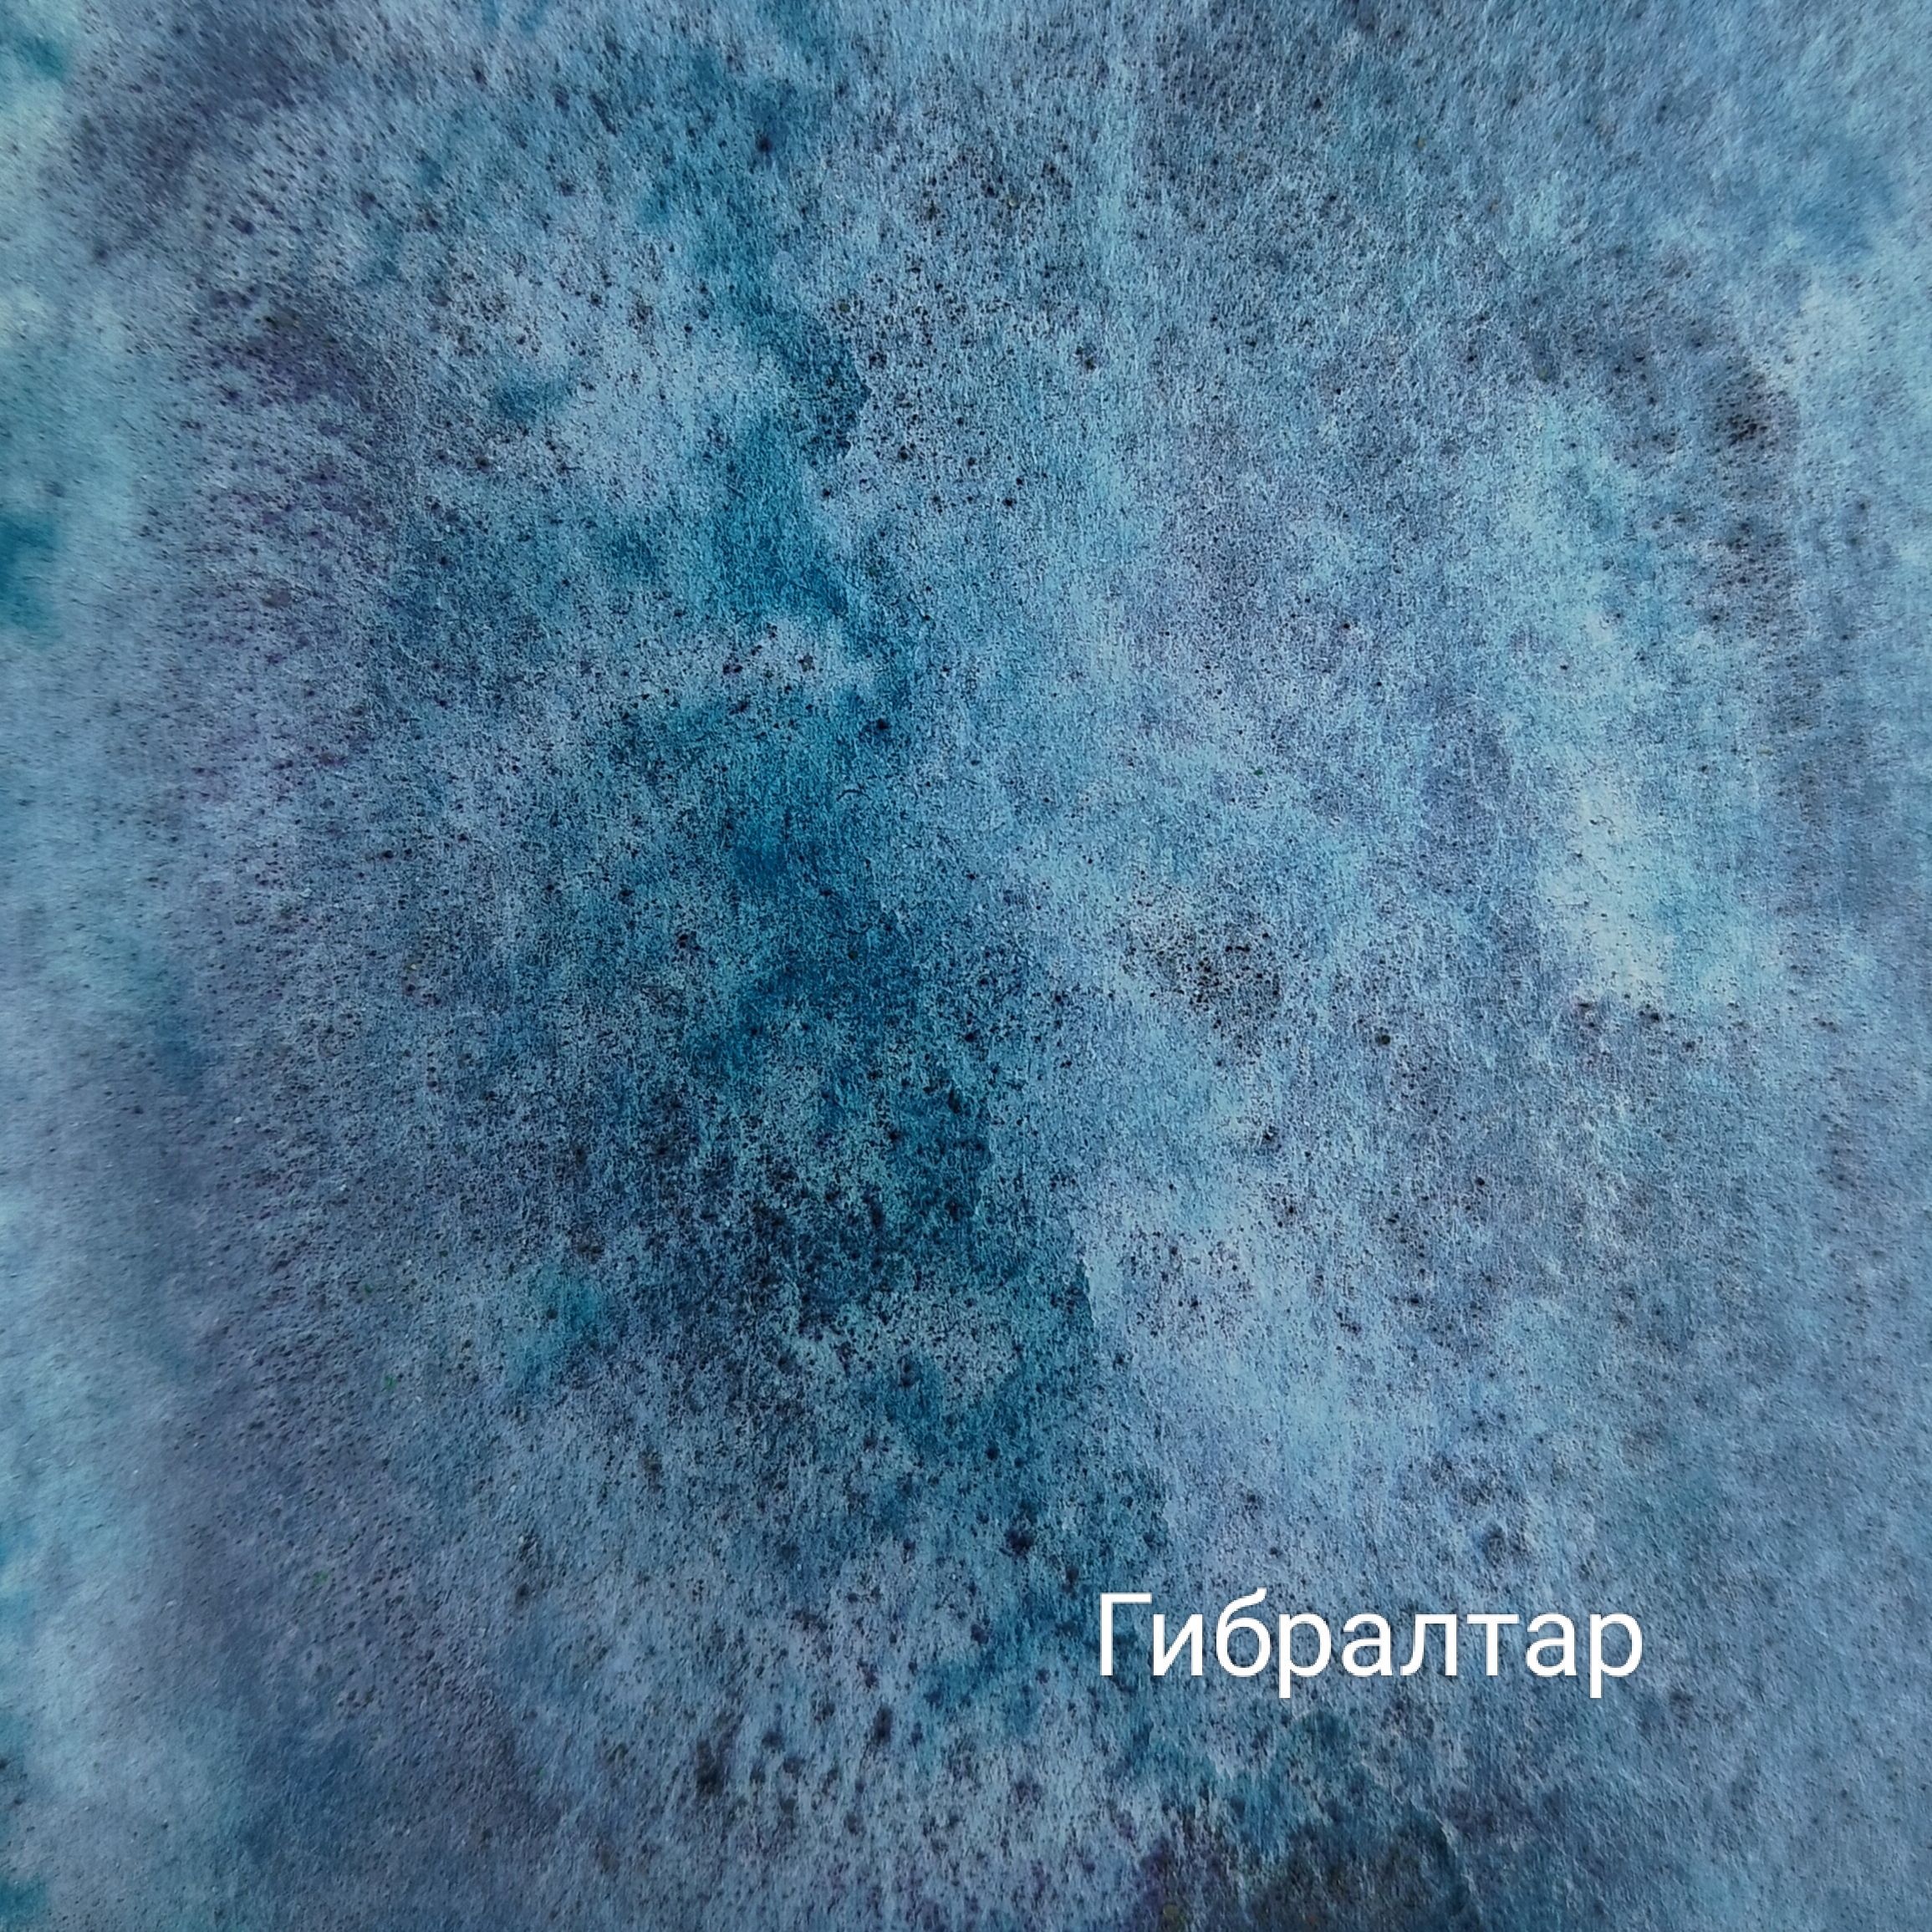

Акварель с грануляцией
Напульсники для спорта
Интернет магазин новогодних гирлянд
Имя лазар
Хотела уточнить где
Звук эй ты
Цель для проекта игра
Сегодня мне не лень
Договор взаимовыгодного сотрудничества
Облака подо мной стрелы
Валио вакансии
Какие языки являются объектно ориентированные
Реалм джи ти
Улик сколько меда
Акварель с грануляцией 109 фотографий